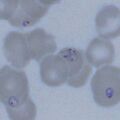

Uncategorized files
Showing below up to 50 results in range #51 to #100.
-
4 PF gametocyte a.jpg 472 × 472; 57 KB
-
4 PF gametocyte anno.jpg 472 × 472; 59 KB
-
4 PF gametocyte b.jpg 472 × 472; 57 KB
-
4 PF gametocyte b anno.jpg 472 × 472; 62 KB
-
4 PF gametocyte b detail.jpg 472 × 709; 104 KB
-
4 PO schizontLT.jpg 472 × 472; 49 KB
-
4 PO schizorLT anno.jpg 472 × 472; 50 KB
-
4 PO schizorLT detail.jpg 472 × 709; 75 KB
-
4 PV ET.jpg 472 × 472; 50 KB
-
4 PV ET anno.jpg 472 × 472; 52 KB
-
4 PV ET detail.jpg 472 × 709; 94 KB
-
4 PV schizont-anno.jpg 472 × 472; 47 KB
-
4 PV schizont.jpg 472 × 472; 49 KB
-
4 PV schizont or LT.jpg 472 × 472; 53 KB
-
4 PV schizont or LT anno.jpg 472 × 472; 55 KB
-
4 RDT work.jpg 413 × 236; 45 KB
-
4 schiz PV.jpg 472 × 472; 45 KB
-
4 schiz PV anno.jpg 472 × 472; 47 KB
-
4 schiz PV detail.jpg 472 × 709; 81 KB
-
5SizePOET.jpg 472 × 472; 69 KB
-
5 PM gametocyte.jpg 472 × 472; 51 KB
-
5 PM gametocyte anno.jpg 472 × 472; 52 KB
-
5 PM gametocyte detail.jpg 472 × 709; 110 KB
-
5 PO gametocyte.jpg 472 × 472; 58 KB
-
5 PO gametocyte anno.jpg 472 × 472; 59 KB
-
5 PO gametocyte detail.jpg 472 × 709; 81 KB
-
5 Pigment neut.jpg 472 × 472; 61 KB
-
5 Pigment neut anno.jpg 472 × 472; 62 KB
-
5 Pigment neut detail.jpg 472 × 709; 78 KB
-
6SizePOLT.jpg 472 × 472; 55 KB
-
7SizePVET.jpg 472 × 472; 55 KB
-
8SizePVLT.jpg 593 × 591; 93 KB
-
Ageing.jpg 472 × 472; 62 KB
-
Amoeboid1.jpg 472 × 472; 30 KB
-
Amoeboid2.jpg 472 × 472; 31 KB
-
Bab complex 1.jpg 472 × 472; 96 KB
-
Bab complex 2.jpg 472 × 472; 118 KB
-
Bab free 1.jpg 472 × 472; 96 KB
-
Bab free 2.jpg 472 × 472; 118 KB
-
Bab simple 1.jpg 472 × 472; 109 KB
-
Bab simple 2.jpg 472 × 472; 102 KB
-
Bab simple 3.jpg 472 × 472; 95 KB
-
Bab simple 4.jpg 472 × 496; 103 KB
-
BasketPM.jpg 472 × 472; 57 KB
-
Biology.jpg 472 × 472; 40 KB
-
Biology Gametocyte.jpg 444 × 472; 66 KB
-
Blood stages schizonts only.jpg 472 × 472; 77 KB
-
Celtic cross 1.jpg 472 × 472; 37 KB
-
Celtic cross 2.jpg 472 × 472; 33 KB
-
Celtic cross 3.jpg 472 × 472; 33 KB